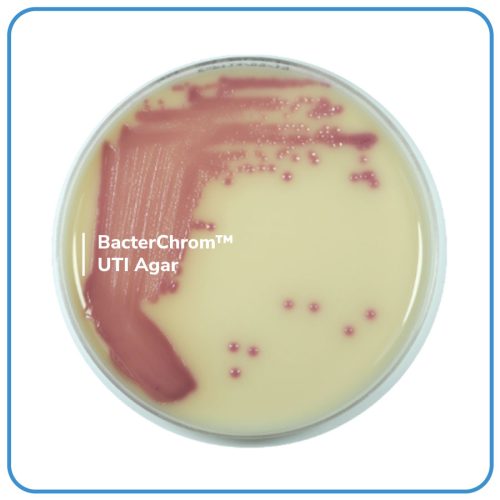

BacterChrom™ UTI Agar
Mã: 01012
Mã đặt hàng/sản phẩm: 4101006
Số lượng tối thiểu: 1
- Môi trường thạch sinh màu sẵn sàng sử dụng trên đĩa Petri 90mm dành cho việc phân lập và phân biệt các vi sinh vật gây bệnh đường tiết niệu.
- Thành phần trong 1L môi trường (tham khảo): Peptone: 16,0g; Growth factor: 13,0g; Chromogenic mix: 0,5g; Tryptophan: 2,0g; Agar: 16,0g. pH của môi trường hoàn chỉnh ở 25°C: 6,8 ± 0,2.
- Quy cách: 10 đĩa/ hộp hoặc theo yêu cầu của khách hàng.
- Bảo quản lưu trữ: 2 – 8°C.
- Vận chuyển: Nhiệt độ môi trường.
- Hạn sử dụng: 04 tháng kể từ ngày sản xuất.
Danh sách đặt hàng

BacterChrom™ UTI Agar
Mã: 4101006
Đơn vị: Đĩa
| Tên sản phẩm | Hình ảnh | Mã đặt hàng/sản phẩm | Đơn vị tính | Số lượng | Chọn vào giỏ hàng |
|---|---|---|---|---|---|
| BacterChrom™ UTI Agar | | 4101006 | Đĩa |
